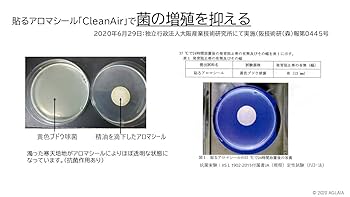

マイストア
変更
お店で受け取る
(送料無料)
配送する
納期目安:
2025.10.24 17:53頃のお届け予定です。
決済方法が、クレジット、代金引換の場合に限ります。その他の決済方法の場合はこちらをご確認ください。
※土・日・祝日の注文の場合や在庫状況によって、商品のお届けにお時間をいただく場合がございます。
特価 ピタっとアロマクリア29Φ100シート Amazon | アグライア ピタッとアロマ クリア 60枚 | アグライアの詳細情報
Amazon | アグライア ピタッとアロマ クリア 60枚 | アグライア。Amazon | アグライア ピタッとアロマ クリア 60枚 | アグライア。Kobe Aroma Company / ピタッとアロマ(貼るアロマシール)small。ピタッとアロマ(シール)|香りを持ち運べる便利な精油専用。特価貼るアロマシール業務用50シート×2パック- 数量: 100シート入り- 形状: 円形- 色: 白- 包装: 透明袋入り好きな香りをつけて衣服やマスクなどに貼ることができます特許取得済み
ベストセラーランキングです
近くの売り場の商品
カスタマーレビュー
オススメ度 4.2点
現在、4112件のレビューが投稿されています。